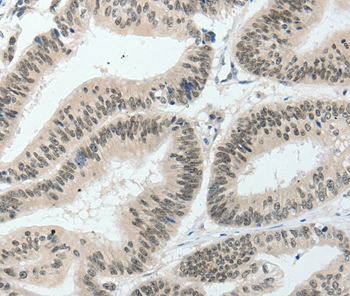

HNF1B Recombinant Antibody
BSM-61983R
ApplicationsWestern Blot
Product group Antibodies
ReactivityHuman
TargetHNF1B
Overview
- SupplierBioss
- Product NameHNF1B Recombinant Antibody
- Delivery Days Customer16
- ApplicationsWestern Blot
- Applications SupplierWB(1:300-5000)
- CertificationResearch Use Only
- ClonalityMonoclonal
- ConjugateUnconjugated
- Gene ID6928
- Target nameHNF1B
- Target descriptionHNF1 homeobox B
- Target synonymsADTKD3, FJHN, HNF-1-beta, HNF-1B, HNF1beta, HNF2, HPC11, LF-B3, LFB3, MODY5, RCAD, T2D, TCF-2, TCF2, VHNF1, hepatocyte nuclear factor 1-beta, HNF1 beta A, homeoprotein LFB3, transcription factor 2, hepatic
- HostRabbit
- IsotypeIgG
- Protein IDP35680
- Protein NameHepatocyte nuclear factor 1-beta
- ReactivityHuman
- Storage Instruction-20°C
- UNSPSC41116161